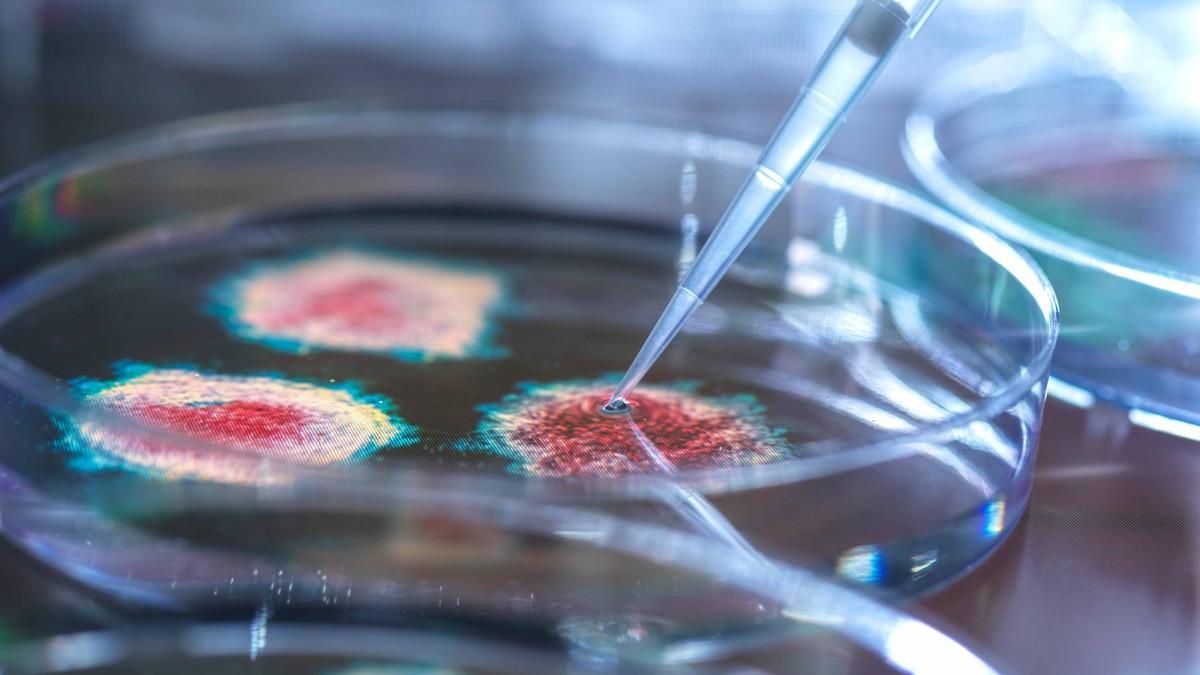
Corona: अपनी कमजोर इम्युनिटी को कैसे पहचानें, ये हैं 5 लक्षण

Corona: अपनी कमजोर इम्युनिटी को कैसे पहचानें, ये हैं 5 लक्षण
AajTak
अच्छी इम्युनिटी हमारे सेल्स को वायरस से लड़ने की क्षमता देती है. अगर हमारी इम्युनिटी मजबूत है तो हम आसानी से कोरोना को हरा सकते हैं. इम्युन सिस्टम कमजोर होने के कई कारण हो सकते हैं. आइए जानते हैं कि कमजोर इम्युनिटी का कैसे पता लगाएं.
कोरोना वायरस की दूसरी लहर से लोग बेहाल हैं. कई वैक्सीन भी आ गई हैं. लेकिन हर कोई इम्युनिटी बढ़ाने की सलाह दे रहा है. लेकिन सवाल यह है कि आप अपनी इम्युनिटी कमजोर है या मजबूत, इसे कैसे जान सकते हैं. इम्यून सिस्टम कमजोर होने के कई कारण हो सकते हैं. आइए विशेषज्ञ से जानते हैं कि कमजोर इम्युनिटी के बारे में कैसे पता लगाएं. प्राकृतिक तौर पर सामान्य बच्चों में इतनी इम्युनिटी होती है कि वो कई तरह के संक्रमण से बिना दवा की मदद से भी लड़ लेते हैं. लेकिन कई बार हमारी लाइफस्टाइल और समस्याएं भी इम्युनिटी को कमजोर कर देती हैं. इससे वायरस से नुकसान का खतरा बढ़ जाता है. इसमें एक वजह यह होती है कि अगर कोई व्यक्ति पहले से किसी बीमारी से जूझ रहा है तो उसमें इम्युनिटी कम होती है. इसके अलावा नशे की लत जैसे धूम्रपान या शराब से भी यह कम हो जाती है. कई लोगों में नींद न आने की समस्या या खानपान सही न होने से भी इम्युन सिस्टम कमजोर होता है. न्यूट्रिशियनिस्ट, डाइटिशियन और फिटनेस एक्सपर्ट मनीषा चोपड़ा के अनुसार अगर आपके शरीर में कमजोर इम्युनिटी के ये पांच लक्षण दिखते हैं तो आपको इम्युनिटी बढ़ाने की जरूरत है.More Related News

इलेक्ट्रिक गाड़ियों के साथ सबसे बड़ी चुनौती उन्हें चार्ज करने की होती है. रेंज एंजायटी जैसे शब्द इसी चिंता से निकले हैं, जहां लोगों को ये डर सताता रहता है कि जाने कब उनकी कार बंद हो जाए और उसे चार्ज कहां करेंगे. इसका निदान चीनी कंपनियां तेजी से खोज रही हैं. एक चीनी कंपनी ने सिर्फ 11 मिनट में फुल चार्ज होने वाली सोडियम-आयन बैटरी तैयार की है.












